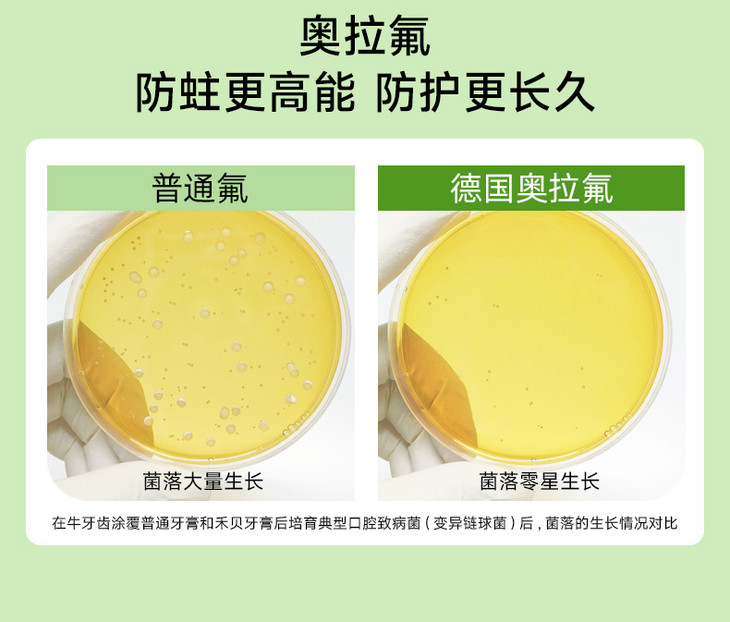

//【禾贝儿童防蛀牙膏】品牌直发⚠2支💰27.9!保价双十一❗ 26年老国货禾贝儿童防蛀牙膏!活性奥拉氟,防蛀固齿,拒绝各种口腔问题 ✅双氟加持,0.07%氟,奥拉氟更防蛀
| 运费: | 免运费 |
| 库存: | 600 件 |
商品详情

不是贵牙膏买不起 是咱们禾贝更有性价比 现在的孩子,10牙9蛀❗ 不爱刷牙、不会刷牙,还爱吃甜食零食,牙齿经常清洁不到位,年纪不大就一口烂牙🥲



点名安利这款禾贝儿童防蛀牙膏

这是一款专门针对蛀牙、口臭等口腔问题设计的口腔护理产品,蕴含多种有效成分 ✌温和有效清洁口腔、清新口气、防蛀防护,帮助维持口腔卫生,长效护齿✌ ✅牙齿脏牙黄适用,清洁口腔、减少软垢 ✅牙洞牙缝蛀牙适用,全面包裹牙齿、强效防蛀 ✅口臭适用,清新口气,长效留香

✅德国进口奥拉氟,防蛀能力强又安全 里面的德国进口【奥拉氟】成分是一种活性氟 活性更强、延展性更高,没刷到、漏刷的地方也容易被包裹到 它能更好地! 高效抵御酸侵蚀,防蛀更高效更高能、防护更全面更长久! 0.07%的含氟量,符合新国际规定的儿童牙膏含氟量 成分精准更安全 坚持使用,孩子牙齿更健康更坚固👍



✅成分温和、安全、可吞咽 给娃买牙膏的时候,好选择低泡沫配方的 禾贝的这款儿童牙膏就采用了低泡设计 氨基酸表活配方➕天然水合硅石, 每次刷牙的时候泡沫不多不少 不刺激牙齿不磨损牙釉质 对孩子口腔黏膜和牙釉质都是安全0刺激 不管是乳牙还是恒牙,都全方位防护


✅天然水果味,口感清爽甜香🥰 不辣嘴不刺激,味道甜甜的 孩子喜欢也不抗拒刷牙了😊 平时吃甜的吃冰的也不怕牙酸牙软了! 关键是,好用还不贵!


✅D音/T猫热卖1⃣0⃣0⃣➕万单

👍回购率&好评率💯



为什么禾贝儿童防蛀牙膏 会被这么多人喜爱❤呢? 当然是有理由的❗



现在的娃真的是条件好了 家里的零食🍭🍧🍩也是一堆堆的。。。 一停下来就在炫零食,还非甜的不吃 时间久了总会引发各种牙齿问题 牙齿刷不干净,导致细菌残留从而形成蛀牙 不良的咀嚼习惯也会引发龋齿 尤其是换牙之后就是一辈子的事了 一口烂牙还会影响食欲影响发育,口臭也易引起同龄人嘲笑 想要牙齿健康,爸爸妈妈日常就要重视起来 帮助他们养成良好的刷牙习惯、防护到位

⚠这款牙膏 完全不会辣口刺激 自从用了它,我家娃每天都主动刷牙 刷完嘴巴里香香甜甜的 而且成分和防蛀效果也非常能打 平时刷不到的牙缝和边边角角都能保护到 不给细jun和腐蚀一点机会 去看白大褂👨,也夸孩子牙齿防护的很好!👍

特地要了他家的检测报告 牙釉质再矿化提升20.73% 真硬核防蛀❗

坚持每天刷牙2次,给牙齿提供七大呵护 ✅强化牙釉质 ✅修复牙齿敏感部位 ✅帮助减少牙jun斑 ✅清新口气 ✅清洁牙齿 ✅呵护牙龈 ✅健白亮齿 🌟牙齿没有烦恼!吃麻麻香~🌟 都是为了孩子好,真的不能忽视孩子的牙齿呀! 有娃的放心入这个!







【品名】禾贝儿童防蛀牙膏
【品牌】禾贝
【口味】阳光草莓味、阳光香橙味
【规格】50g*2支
【净含量】50g/支
【生产日期】2024年7月
【保质日期】3年
【生产产地】广东佛山
【发货地点】广东广州、江西九江、新疆
【执行标准】GB/T 【功效执行标准】QB/T
【储存方法】放置常温干燥处,避免阳光直射并远离高温
【使用方法】建议早晚刷牙,取适量牙膏挤于牙刷上,使用正确刷牙方法,每次2~3分钟,刷完后用清水漱口。
【注意事项】请在成人监护下使用,不能食用,谨防吞咽。
【发货时效】24-72小时
【发货快递】三通一达、极兔随机发货
【不发货地区】港澳台
【售后说明】支持7天无理由退货,质量问题由卖家承担退回运费;非质量问题,由买家承担退回运费,不支持拦截与拒收。
- 好物随心
- 扫描二维码,访问我们的微信店铺